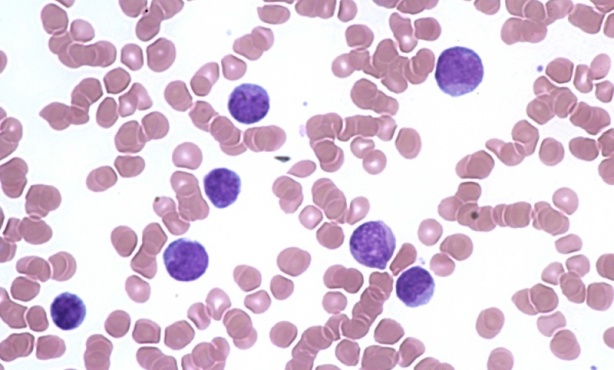

Моноцитна левкемия МКБ C93
Левкемиите представляват малигнени заболявания на кръвта, при които се наблюдава патологична пролиферация на неопластично трансформирани хемопоетични клетки.
Моноцитната левкемия се характеризира с патологично повишен брой на клетките от бялата кръвна редица в костния мозък и периферната кръв.
Основните механизми, които водят до развитието на този тип левкемия, са неконтролиран растеж на моноцитната редица, нарушение в диференциацията, потискане на развитието на нормалните хемопоетични клетки и недостатъчност на костния мозък.
Етиологията на заболяването не е напълно уточнена, но като рискови и провокиращи се обсъждат фактори като генетична предразположеност, хромозомни болести, вродени синдроми, като синдром на Даун, синдром на Блум, излагане на радиация, предшестващо онкологично лечение (например агресивна химиотерапия или високодозова лъчетерапия), вредни влияния от околната среда, професионална експозиция на токсични агенти, пестициди, бензен и други.
Моноцитната левкемия се отличава с ниска честота, относително еднакво засягане на представителите от двата пола и развитие във всички възрастови групи.
Форми и симптоми при моноцитна левкемия
Клиничната картина и характерни симптоми при моноцитна левкемия показват известна вариабилност при отделните пациенти в зависимост от формата на заболяването, степента на прогресия на болестния процес и редица индивидуални особености на конкретния пациент.
В зависимост от протичането и някои морфологични особености заболяването се подразделя на следните форми:
- Остра моноцитна левкемия: нарича се още остра миелоидна левкемия тип М5 или остра монобластна левкемия. Характерна е за детската възраст и съставлява приблизително една пета от всички случаи на остра миелоидна левкемия в педиатрията. При голяма част от пациентите са налице астеноадинамичен синдром, изразен в различна степен, фебрилитет (повишение на телесната температура), чести инфекции (с бактериална или гъбична етиология), повишен риск от кървене (включително кървене от венците, кръвотечения от носа, лесно формиране на синини), неврологична симптоматика. Често се наблюдава и инфилтриране на кожата от левкемичните клетки и хиперплазия на венците. Лечението изисква агресивен подход и интензифицирана полихимиотерапия с определени стандартизирани схеми и дозови режими, като прогнозата често е сериозна (най-голямо значение има терапевтичният отговор спрямо приложените лечебни мероприятия).
- Хронична моноцитна левкемия: Характерна е за възрастта след 60 години, с доминиране в честотата на засягане на мъжкия пол. Налице е моноцитоза, миелодисплазия и липса на хромозомни нарушения. Клиничната картина включва разнообразие от симптоми, свързани с анемията (слабост, лесна уморяемост, бледи кожа и лигавици), тромбоцитопенията (повишена склонност към кървене, лесно формиране на синини) и моноцитозата (склонност към опортюнистични инфекции, фебрилни състояния). Според броя на клетките в костния мозък и периферната кръв, се подразделя на два подтипа. При тип 1 бластите са по-малко от 5 % от клетките на бялата редица в кръвта и по-малко от 10 % от клетките в костния мозък. При тип 2 бластите са 5-20 % от белите клетки в кръвта и от 10 до 20 % от клетките в костния мозък. За лечение се прилага комбиниран, комплексен подход с индивидуализиране на терапевтичния режим.
- Друга моноцитна левкемия: състоянието се характеризира с повишение броя на клетките от моноцитната редица в костния мозък и периферната кръв. Протича с нехарактерни, неспецифини прояви, дължащи се на пораженията върху костномозъчната функционална активност, като лечението често е комбинирано и включва подходяща химиотерапия, симптоматични средства, при възможност и други терапевтични подходи.
- Моноцитна левкемия, неуточнена: при невъзможност за категоризиране и класифициране на левкемията към някоя от гореизброените, се говори за неуточнена моноцитна левкемия.
При прогресия на заболяването, липса на лечение, неподходяща терапия или забавяне в диагностицирането е налице риск от развитие на различни по вид усложнения, много от които показват системен характер, водят до сериозни нарушения на органната активност и влошават прогнозата.
Поставяне на диагнозата
Диагнозата при моноцитна левкемия се поставя след извършането на множество клинико-лабораторни и инструментални изследвания, обстойна обработка на информацията и при необходимост консултация с други специалисти.
Най-общо за откриване на заболяването се прилагат:
- разпит и преглед на пациента: информацията от разпита на пациента и физикалния преглед рядко насочва към някое конкретно заболяване, но могат в макар и редки случаи да подпомогнат установяването на определени рискови фактори, давността на проявите и други
- лабораторни изследвания: лабораторните изследвания включват пълна кръвна картина с диференциално броене, кръвен химичен анализ, натривка от периферна кръв, определяне на коагулационния статус. Често се назначава и проследяване на основните показатели за функционалната активност на бъбреците и черния дроб
- биопсия от костен мозък: за потвърждение на диагнозата е необходимо изследване на костен мозък, получен чрез аспирационна биопсия. Провежда се имунохистохимичен и цитогенетичен анализ, като по преценка на лекуващия лекар в някои случаи може да се назначи и извършване на лумбална пункция и изследване на материала
- образна диагностика: при съмнения за разпространение на процеса и ангажиране на вътрешните органи или ЦНС, е необходимо провеждане на КТ (компютърна томгорафия) или ЯМР (ядрено-магнитен резонанс), рядко се прилагат други образни методи на изследване
Диференциалната диагноза при моноцитна левкемия налага разграничаване от другите видове левкемия, системни процеси, ангажиращи костния мозък, както и някои по-редки заболявания на лимфните и кръвотворните тъкани.
Лечение при моноцитна левкемия
Лечението на пациенти с моноцитна левкемия е комплексно и включва симптоматични средства, комбинирана полихимиотерапия, заместително лечение с растежни фактори, алогенна трансплантация на костен мозък, като изборът на конкретна терапевтична схема се определя индивидуално при всеки отделен пациент в зависимост от особеностите на протичането на левкемията, както и от редица индивидуални фактори (възраст, общо състояние, подлежащи заболявания, алергии и други):
- химиотерапия: обикновено се предпочита комбинирана полихимиотерапия с използване на повече от един препарат (в зависимост от използваните схеми могат да се прилаг между четири и шест различни препарата за постигане на по-голям ефект и намаляване риска от лекарствена резистентност). Химиотерапията често се комбинира с кортикостероиди, като в зависимост от препаратите терапията се прилага парентерално (по-често) и/или перорално (само някои лекарства са ефективни при прием през устата)
- имунотерапия: изпозлването на биологични лекарства, моноклонални антитела, инхибитори на определени протеини, ензими, растежни фактори и други при някои пациенти показва задоволителни резултати, но следва да се имат предвид възможните рискове от странични ефекти
- трансплантация на костен мозък: в определени случаи се прилага (при възможност и очакване на добър ефект) трансплантация на костен мозък или стволови клетки, като пациентите следва да отговарят на определени стандартизирани критерии и процедурата обикновено се комбинира с подходяща химиотерапия
- симптоматични средства: успоредно с избраната терапевтична антинеопластична терапия се прилагат различни лекарства и методи за подобряване комфорта, симптомите, психичното и емоционалното състояние на пациентите, като се използват препарати от различни фармакологични групи (аналгетици, антиеметици, антипсихотици и други) и средства от алтернативната медицина (техники за релаксация, медитация и други)
Прогнозата при пациентите с моноцитна левкемия се определя индивидуално, в зависимост от редица фактори, като с най-голямо значение са възрастта и състоянието на болния, формата и тежестта на заболяването и отговорът към приложената схема на лечение.
Заглавно изображение: Guy Waterval, Apache License 2.0, via Wikimedia Commons
Коментари към Моноцитна левкемия МКБ C93